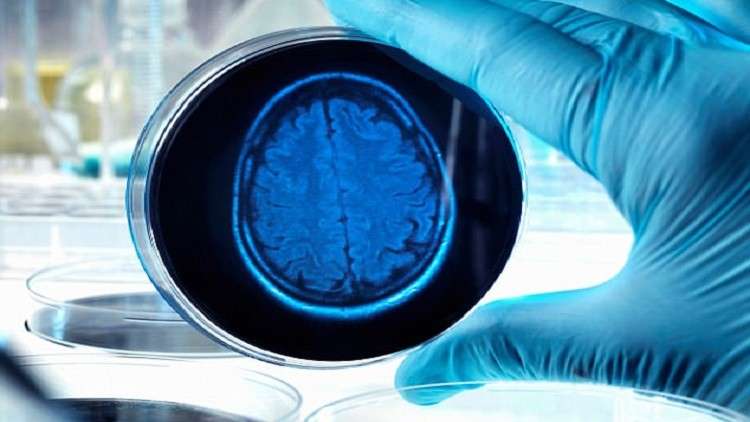

المرض المدمر.. العلماء يحددون العلامة المبكرة لاحتمال الإصابة
المشهد الجنوبي الأول | منوعات
إذا كنت تكافح من أجل قراءة كلمات بسيطة، فقد يكون ذلك علامة مبكرة على الإصابة بالخرف.
وقال العلماء إن استجابة الدماغ المتأخرة لمعالجة الكلمات قد يكون إشارة تبلّغ عن إمكانية تعرض أولئك الأفراد للإصابة بالأمراض العصبية حتى قبل بدء ظهور أعراض هذه الأمراض.
ويأمل الباحثون في أن تمهد النتائج الطريق لإجراء اختبار قراءة بسيط يمكنه تحديد الأشخاص المعرضين لخطر الإصابة بمرض ألزهايمر.
وهذا ما من شأنه أن يسمح بالتشخيص المبكر للمرض، وهو الهدف الذي يسعى العلماء إلى تحقيقه منذ سنوات، وإن كان دون جدوى.
وتقدم الدراسة التي أشرف عليها خبراء في جامعة برمنغهام، الأمل في إمكانية العثور على علاج للخرف في غضون السنوات المقبلة.
وشارك نحو 25 شخصا في الدراسة، حيث كان على المشاركين قراءة كلمات مكتوبة تتعلق بعبارات سمعوها قبل ذلك بلحظات.
وأظهر المسح الدماغي أن الاستجابات البطيئة للقراءة رُصدت لدى الأشخاص الذين لديهم احتمال الإصابة بمرض ألزهايمر لاحقا، وقالت الدكتورة كاتريان سيجايرت، المؤلفة الرئيسية للدراسة: “كانت نتائجنا غير متوقعة لأن اللغة عادة ما تتأثر بالألزهايمر في مراحلة متقدمة جدا من بداية المرض، ومن الممكن أن يكون هذا الانهيار لشبكة الدماغ المرتبطة باللغة، علامة حاسمة تستخدم في تحديد الأشخاص المحتملين لتطور مرض ألزهايمر”.
وقالت كلير والتون، مديرة الأبحاث في جمعية الألزهايمر إن: “البحوث من هذا القبيل تعطينا الأمل في إيجاد وسيلة لتشخيص المرض في وقت مبكر”، ومع ذلك، حذرت من أنه من السابق لأوانه استخلاص أي استنتاجات ثابتة، وأنه من الواضح أن هناك حاجة إلى دراسات أكبر لتأكيد النظرية.
ويقدر المسؤولون بأن هناك حوالي 47 مليون مصاب بالخرف في جميع أنحاء العالم مع ما يقارب 10 ملايين حالة جديدة يتم الإبلاغ عنها كل عام.
ومن شأن التشخيص المبكر لهذا المرض المدمر، الذي هو حاليا غير قابل للشفاء، أن يعطي أملا في وصف الأدوية الملائمة لتحسين عمل الدماغ والتشجيع على تغيير نمط الحياة الذي يمكن من خلاله تجنب الخرف.
المصدر: ديلي ميل